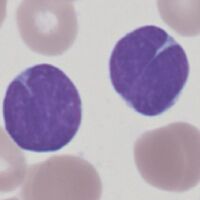

Flow cytometry: Follicular Lymphoma
From haematologyetc.co.uk
Background
Follicular lymphoma expresses CD10, with other immunophenotypic featues differing from related disorders.
However, individual markers may not be expressed in all cases - confirmation can be made from histopathology, cytogenetic or genetic testing.
| Immunophenotype of FL | |||
|---|---|---|---|
| CD45 expression | |||
| Typically expression of CD45 approaches that of normal T and B cells. | |||
| Major markers useful in diagnosis | |||
| Marker | Freq | Level | Comment |
| κ/λ | Expect κ or λ expression, undetectable in rare cases | ||
| CD19 | - | Expression is expected, but may be weak or undectable | |
| CD5 | - | Expression of CD5 is characteristic of MCL | |
| CD10 | Strg | Expression is expected though not universal in FL | |
| CD23 | - | May be expressed by some cases of FL | |
| CD79b | Expression is expected and should be stronger than CLL | ||
| CD200 | - | Characteristically (though not always) negative in FL | |
| FMC7 | - | Occasionally seen, FMC7 is not typical of FL | |
| Other relevant markers | |||
| CD11C | Expression is not typically seen in FL | ||
| CD20 | - | Expression is expected, rare cases may have CD20 loss | |
| CD25 | Not typical of FL, where present it is not generally strong | ||
| CD38 | - | Expression is expected in FL but CD138 should be absent | |
| CD43 | - | Expression is uncommon in FL, may be helpful in some cases | |
| CD103 | - | Not expressed by FL, consider HCL if found | |
| CD138 | - | Predominantly expressed at plasma cell differentiation | |
Key to table:
Key to colour code for expression frequency Click for link
Key to expression strength code and use Click for link